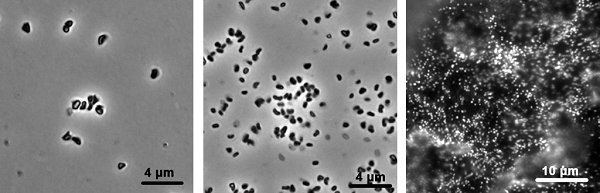
メタン菌顕微鏡写真

NBRCニュース 第43号
◆◇◆ ━━━━━━━━━━━━━━━━━━━━━━━━━━━━━━━━ ◆◇◆
NBRCニュース No. 43(2017.2.1)
◆◇◆ ━━━━━━━━━━━━━━━━━━━━━━━━━━━━━━━━ ◆◇◆
NBRCニュース第43号をお届けします。今号は微生物あれこれ、バイテク分析法の2つの
連載をお届けします。最後までお読みいただければ幸いです。
================================================================================
内容
================================================================================
1.新たにご利用可能となった微生物株
2.微生物あれこれ(39)まだまだ広がる?メタン菌の多様性
3.バイテク分析法(3)細菌の分類同定における全ゲノム配列の利用
4.海外資源へのアクセスに関する国別情報
5.平成29年度海外微生物探索に関する共同事業先の公募のお知らせ
6.年度切替作業によるNBRC微生物株・DNAリソースの発送休止について
7.NITEバイオテクノロジーセンター展示のお知らせ
================================================================================
1.新たにご利用可能となった微生物株
================================================================================
◆ NBRC株、ゲノムDNA
酵母 56株、糸状菌 3株、細菌 20株、アーキア 30株、微細藻類 2株、ゲノムDNA 2種類
が新たにご利用可能となりました。
酵母では南極の土壌から分離されたCystobasidium属の新種で、氷点下でも生育可能な
Cystobasidium tubakii NBRC 112503とC. ongulense NBRC 112505を公開しました。
細菌では南極の赤雪から分離されたHymenobacter nivis NBRC 111535や、代表的なウシ
の病原菌であるActinomyces bovis NBRC 112524を公開しました。
【詳細】 https://www.nite.go.jp/nbrc/cultures/nbrc/new_strain/new_dna.html
◆ RD株
ベトナムの植物および腐朽木から分離された糸状菌210株を追加しました。是非、リス
トをご覧ください。
【詳細】 https://www.nite.go.jp/nbrc/cultures/rd/new_rd.html
【RD株リスト】 https://www.nite.go.jp/nbrc/cultures/rd/available_rd_list.html
================================================================================
2.微生物あれこれ(39)
まだまだ広がる?メタン菌の多様性 (森 浩二)
================================================================================
石炭を食べるメタン菌Methermicoccus shengliensisの存在がScience誌で報告されまし
た(1)。メタン菌を長く取り扱っているものにとって、ちょっと驚きのニュースです。
メタン菌は、嫌気環境下においてメタン生成を伴った呼吸様式によりエネルギーを獲得
する微生物群の総称で、系統的にアーキア(古細菌)のユーリアーキオータ門に属し、現
在までに34属157種が知られています。ユーリアーキオータ門は巨大な系統群であり、そ
の門内に散在するメタン菌は16S rRNA遺伝子配列において極めて多様な微生物群です。そ
の存在は、陸水から海洋・高塩環境、低温から高温環境、酸性からアルカリ環境まであり
とあらゆる嫌気環境で確認されており、嫌気的な物質分解の最終段階を担っています。微
生物における最高記録である122度の超高温環境で増殖可能なMethanopyrus kandleriや、
pH 10という超アルカリ環境で増殖可能なMethanosalsum natronophilumなど激烈な環境で
も逞しく生息するメタン菌もいます。その幅広い生息環境は、メタン菌が現地球環境にお
いて必要不可欠な存在であり、地球史おいて一過性の存在では無かったことを示している
と思います。
あらゆる嫌気環境に生息するメタン菌ですが、熱水域などの水素と二酸化炭素が豊富な
特殊環境での増殖を除けば、その役割は一貫して嫌気環境における物質分解の最終段階を
担うことにあり、メタン生成の基質は水素+二酸化炭素、酢酸、メタノールまたはメチル
アミン類という単純な物質に限られていました。一方で、新たに発見されたM. shengli-
ensisは石炭に含まれる、より複雑な物質であるメトキシ芳香族化合物をメタン生成の基
質としています。この菌のメタン生成経路はまだ明らかにされていませんが、これまでに
知られているメタン生成経路とはちょっと違うようです。このメタン菌だけが特別な存在
なのか、既知種を含め同様なメタン生成経路を持つメタン菌が他にも存在するのか、非常
に興味深いです。また他方では、鉄を使って増殖するメタン菌Methanococcus maripalu-
dis も報告されています(2)。このメタン菌は鉄から水素を作り、自ら生成した水素を
使って増殖します。特殊なヒドロゲナーゼを使って水素生産をしていると考えられます
が、詳細な水素生産機構はまだ分かっていません。他の細菌が排出した水素や自然界から
偶発的に生産される水素を利用しているイメージが強いメタン菌ですが、能動的に水素を
作っている振る舞いはメタン菌の新たな一面と言えます。
石炭を食べるメタン菌や鉄をエネルギー源とするメタン菌の存在は、メタン菌のエネル
ギー獲得方法がこれまで考えられていたよりも実はもっと多様であり、様々なオプション
機能があることを示しているのかもしれません。確立したメタン生成回路を携えて生息圏
を拡大してきたメタン菌ですが、そのエネルギー獲得様式もしっかりと進化させているよ
うです。
NBRCでは石炭を食べるメタン菌(Methermicoccus shengliensis、NBRC 112467)や超ア
ルカリ環境で増殖可能なメタン菌(Methanosalsum natronophilum、NBRC 110091)、鉄を
使って増殖するメタン菌(Methanococcus maripaludisの一部、NBRC 102054など)を含
め、多数のメタン菌を取りそろえております。是非ご利用ください。

(左)Methermicoccus shengliensis NBRC 112467
(中)Methanosalsum natronophilum NBRC 110091
(右)鉄に付着するMethanococcus maripaludis
【文献】
(1) Mayumi, D. et al. (2016). Science, 354, 222-225.
(2) Uchiyama, T. et al. (2010). Appl. Environ. Microbiol., 76, 1783-1788.
================================================================================
3.バイテク分析法(3)
細菌の分類同定における全ゲノム配列の利用 (山副敦司)
================================================================================
現在の細菌同定において一般的に用いられている16S rRNA遺伝子の塩基配列の系統解析
では、明確に区別できない種も増えています(1)。このような分類群を対象に同定を行う
場合、近縁種と同種であるか否かの判断をDNA-DNA ハイブリダイゼーション(DNA-DNA
Hybridization; DDH)試験等により行う必要があります。また、細菌における種の概念
は、国際原核生物分類命名委員会により「DDH試験によるDNA配列の相同性が70%以上の菌
株の集団」として定義されていることから(2)、16S rRNA遺伝子の類似度から明らかに別
種と考えられる場合を除き、DDH試験は新種提案を行ううえで欠かせない実験となってい
ます。
しかし、DDH試験は実験操作が煩雑で試験条件(抽出DNAの品質やハイブリダイゼーショ
ン温度等)による影響も受けやすく、再現性の良いデータを得るには熟練を要します。ま
た、DDH試験では1対1での比較を行うため、分類対象に数多くの近縁種が存在する場合、
非常に手間と時間がかかります。そこで、近年のゲノム解析の低価格化や急速なゲノム配
列情報の蓄積等もあり、DDH試験の代替法として、全ゲノム配列を利用したゲノム全体で
の類似性を指標にした新たな分類方法(overall genome relatedness indices;OGRI)の
開発に期待が寄せられています(3)。
現在、OGRIで利用されている手法として、ゲノム配列の相同性をコンピューター上で解
析するin silico DDH法があります。その中でも、2つのゲノム配列上のオーソログな領域
における相同値の平均値を計算する方法であるANI(Average Nucleotide Identity)が最
も利用されており、ANI値とDDH相同値には高い相関が確認されています(4)。これまでの
ANI値とDDH相同値との比較に基づき、ANI解析における新種の閾値(DDH相同値70%に相当
する値)は95~96%と考えられており(5,6)、実際の新種記載においてANI解析をDDH試験
の代替法として使用している論文が増えています。ANI値は、DDH実験におけるDNA断片化
工程を模擬するために、比較する双方のゲノム配列をコンピューター上で1020bpに切断し
た後に、blast等の相同性解析ソフトを用いて計算します(ANIb)(5)。また、精度を損な
うことなく計算速度を速める方法としてMUMmerという解析ソフトを用いる方法(ANIm)が
開発されています(6)。ANI解析に使用できるプログラムとしては、JSpeciesやGegeneesが
無料でダウンロードできる他、ANI calculatorやEzGenomeといったオンライン解析プログ
ラムも整備されています。一方で、異なるプログラムを使用した際の結果の違いについて
は十分に検討されておらず、プログラムの違いに起因する誤同定のおそれがあることに注
意しなくてはなりません(7)。
ANI解析以外のin silico DDH法として、ゲノム配列の断片化を行わない代わりに、
blast等のローカルアライメントツールを用いて高い相同性を持つ断片領域を特定し、そ
のペアワイズ距離を求める方法(Genome-to-Genome Distance Calculator;GGDC)(8)や
MUMmerプログラムを用いたペアワイズ解析により、ゲノム間での最大の相違度を求める
MUMi(maximal unique matches index)という方法もあります。特にMUMi値はANI値との
相関性も高く、また、ANI解析では識別が困難な種内(intraspecies)レベルでの解像度
に優れています(9)。
in silico DDH法は、DDH試験に比べ実験者の熟練度を必要としないので、ゲノム配列が
あれば簡単に実施可能です。今後、より多くの分類群でのゲノム情報の蓄積が進むこと
で、広く一般的な方法としての普及が期待されます。
【文献】
(1) Das, S. et al. (2014). J. Microbiol. Methods, 103, 80-100.
(2) Tindall, B.J. et al. (2010). Int. J. Syst. Evol. Microbiol., 60, 249-266.
(3) Whitman, W.B. (2015). Syst. Appl. Microbiol., 38, 217-222.
(4) Konstantinidis, K.T. & Tiedje, J.M. (2005). Proc. Natl. Acad. Sci. USA,
102, 2567-2572.
(5) Goris, J. et al. (2007). Int. J. Syst. Evol. Microbiol., 57, 81-91.
(6) Richter, M. & Rossello-Mora, R. (2009). Proc. Natl. Acad. Sci. USA, 106,
19126-19131.
(7) Beaz-Hidalgo, R. et al. (2015). PLoS One, 10, e0115813.
(8) Meier-Kolthoff, J.P. et al. (2014). Int. J. Syst. Evol. Microbiol., 64,
352-356.
(9) Deloger, M. et al. (2009). J. Bacteriol., 191, 91-99.
【in silico DDH法に使用できるプログラム】
JSpecies : http://www.imedea.uib.es/jspecies
Gegenees : http://www.gegenees.org/documentation.html
ANI calculator : http://enve-omics.ce.gatech.edu/ani/index
EzGenome: http://www.ezbiocloud.net/tools/ani
Genome-to-Genome Distance Calculator: http://ggdc.dsmz.de
================================================================================
4.海外資源へのアクセスに関する国別情報
================================================================================
NBRCでは、生物多様性条約に基づく海外資源へのアクセスに関する情報を提供しており
ます。既に公開しているブラジル、モンゴルに加え、この度ミャンマーの微生物資源への
アクセスに関する情報を公開しました。
詳細は以下をご覧ください。
http://www.nite.go.jp/nbrc/global/countries/Myanmar_cbd.html
================================================================================
5.平成29年度海外微生物探索に関する共同事業先の公募のお知らせ
================================================================================
平成29年度に実施予定の「ミャンマーにおける生物遺伝資源の保全と持続可能な利用に
関する共同事業」において、微生物探索を現地ミャンマーで行う共同事業先を公募いたし
ます。皆様のご応募をお待ちしております。
詳細は以下をご覧ください。
http://www.nite.go.jp/nbrc/global/information/collabo_Myanmar_2017.html
================================================================================
6.年度切替作業によるNBRC微生物株・DNAリソースの発送休止について
================================================================================
年度切替作業にともない、3月末のご依頼は下記の様に対応させていただきます。
発送休止期間:平成29年3月29日(水)~31日(金)
発送予定:
3月27日(月)午前まで受付分 → 3月28日(火) 発送
3月27日(月)午後~31日(金)午前まで受付分 → 4月3日(月)以降順次発送
https://www.nite.go.jp/nbrc/cultures/index.html
================================================================================
7.NITEバイオテクノロジーセンター展示のお知らせ
================================================================================
以下に出展いたします。ブースではお立ち寄りいただいた皆様からのご相談やご質問に
もお答えします。是非お越しください。
日本農芸化学会2017年度大会
日程:平成29年3月17日(金)~20日(月)
場所:京都女子大学、ウェスティン都ホテル京都
(附設展示会会場)京都女子大学体育館(18日~20日)
http://www.jsbba.or.jp/2017/
================================================================================
編集後記
================================================================================
この冬は、NBRCの所在地である千葉県木更津市でも11月下旬に雪が積もるという異常な
スタートを切りました。お正月は暖かかったとはいえ、最近は寒い日が続いております。
例年この時期はインフルエンザが流行しますが、今年はノロウイルスが猛威を振るってい
るそうです。我が家では冬休みの間に子どもが二度も急性胃腸炎にかかりましたが、運良
く他の誰にも感染せず、一家全滅という最悪の事態は免れました。皆様も、くれぐれもご
自愛ください。(MH)
◆◇◆ ━━━━━━━━━━━━━━━━━━━━━━━━━━━━━━━━ ◆◇◆
・画像付きのバックナンバーを以下のサイトに掲載しております。受信アドレス変更、
受信停止も以下のサイトからお手続きいただけます。
https://www.nite.go.jp/nbrc/cultures/others/nbrcnews/nbrcnews.html
・NBRCニュースは配信登録いただいたメールアドレスにお送りしております。
万が一間違えて配信されておりましたら、お手数ですが、下記のアドレスにご連絡く
ださい。
・ご質問、転載のご要望など、NBRCニュースについてのお問い合わせは、下記のアドレ
スにご連絡ください。
・掲載内容は予告なく変更することがございます。掲載内容を許可なく複製・転載され
ることを禁止します。
・偶数月の1日(休日の場合はその前後)に配信します。第44号は2017年3月31日に配
信予定です。
編集・発行
独立行政法人製品評価技術基盤機構(NITE)バイオテクノロジーセンター
NBRCニュース編集局(nbrcnews@nite.go.jp)
◆◇◆ ━━━━━━━━━━━━━━━━━━━━━━━━━━━━━━━━ ◆◇◆
お問い合わせ
-
独立行政法人製品評価技術基盤機構 バイオテクノロジーセンター
生物資源利用促進課
(お問い合わせはできる限りお問い合わせフォームにてお願いします)
-
TEL:0438-20-5763
住所:〒292-0818 千葉県木更津市かずさ鎌足2-5-8 地図
お問い合わせフォームへ